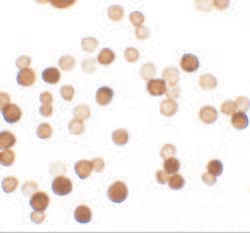
Invitrogen ERRF Polyclonal Antibody 100 &mu;g; Unconjugated:Antibodies,

missing translation for 'onlineSavingsMsg'
Learn More
Learn More
Invitrogen™ ERRF Polyclonal Antibody


Rabbit Polyclonal Antibody
Brand: Invitrogen™ PA534534
This item is not returnable.
View return policy
Description
A suggested positive control is Hela cell lysate. PA5-34534 can be used with blocking peptide PEP-1577.
The estrogen receptor-related factor (ERRF) is a recently identified protein whose expression is upregulated in multiple cell lines and primary breast cancer tumors. Increased ERRF expression was significantly associated with ER or progesterone receptor (PR) positivity even in HER2-negative tumors. This higher ERRF expression correlated with better disease-free survival and overall survival. In two ER-positive breast cancer cell lines, knockdown of ERRF suppressed cell growth in vitro and tumorigenesis in xenograft models, suggesting that ERRF plays a role in estrogen-ER-mediated breast cancer cell growth and may thus be a potential therapeutic target.
Specifications
| ERRF | |
| Polyclonal | |
| Unconjugated | |
| SRARP | |
| C1orf64; chromosome 1 open reading frame 64; ER-related factor; ERRF; Gm694; predicted gene 694; RP11-5P18.4; Srarp; SSPR; Steroid receptor-associated and regulated protein; Steroid receptor-regulated protein; uncharacterized protein C1orf64; uncharacterized protein C1orf64 homolog | |
| Rabbit | |
| Antigen Affinity Chromatography | |
| RUO | |
| 149563, 277744 | |
| Maintain refrigerated at 2-8°C for up to 3 months. For long term storage store at -20°C | |
| Liquid |
| Immunohistochemistry, Western Blot, Immunocytochemistry | |
| 1 mg/mL | |
| PBS with 0.02% sodium azide | |
| Q8NEQ6 | |
| SRARP | |
| A 15 amino acid peptide near the carboxy terminus of human ERRF. | |
| 100 μg | |
| Primary | |
| Human, Mouse | |
| Antibody | |
| IgG |
Product Content Correction
Your input is important to us. Please complete this form to provide feedback related to the content on this product.
Product Title
Spot an opportunity for improvement?Share a Content Correction